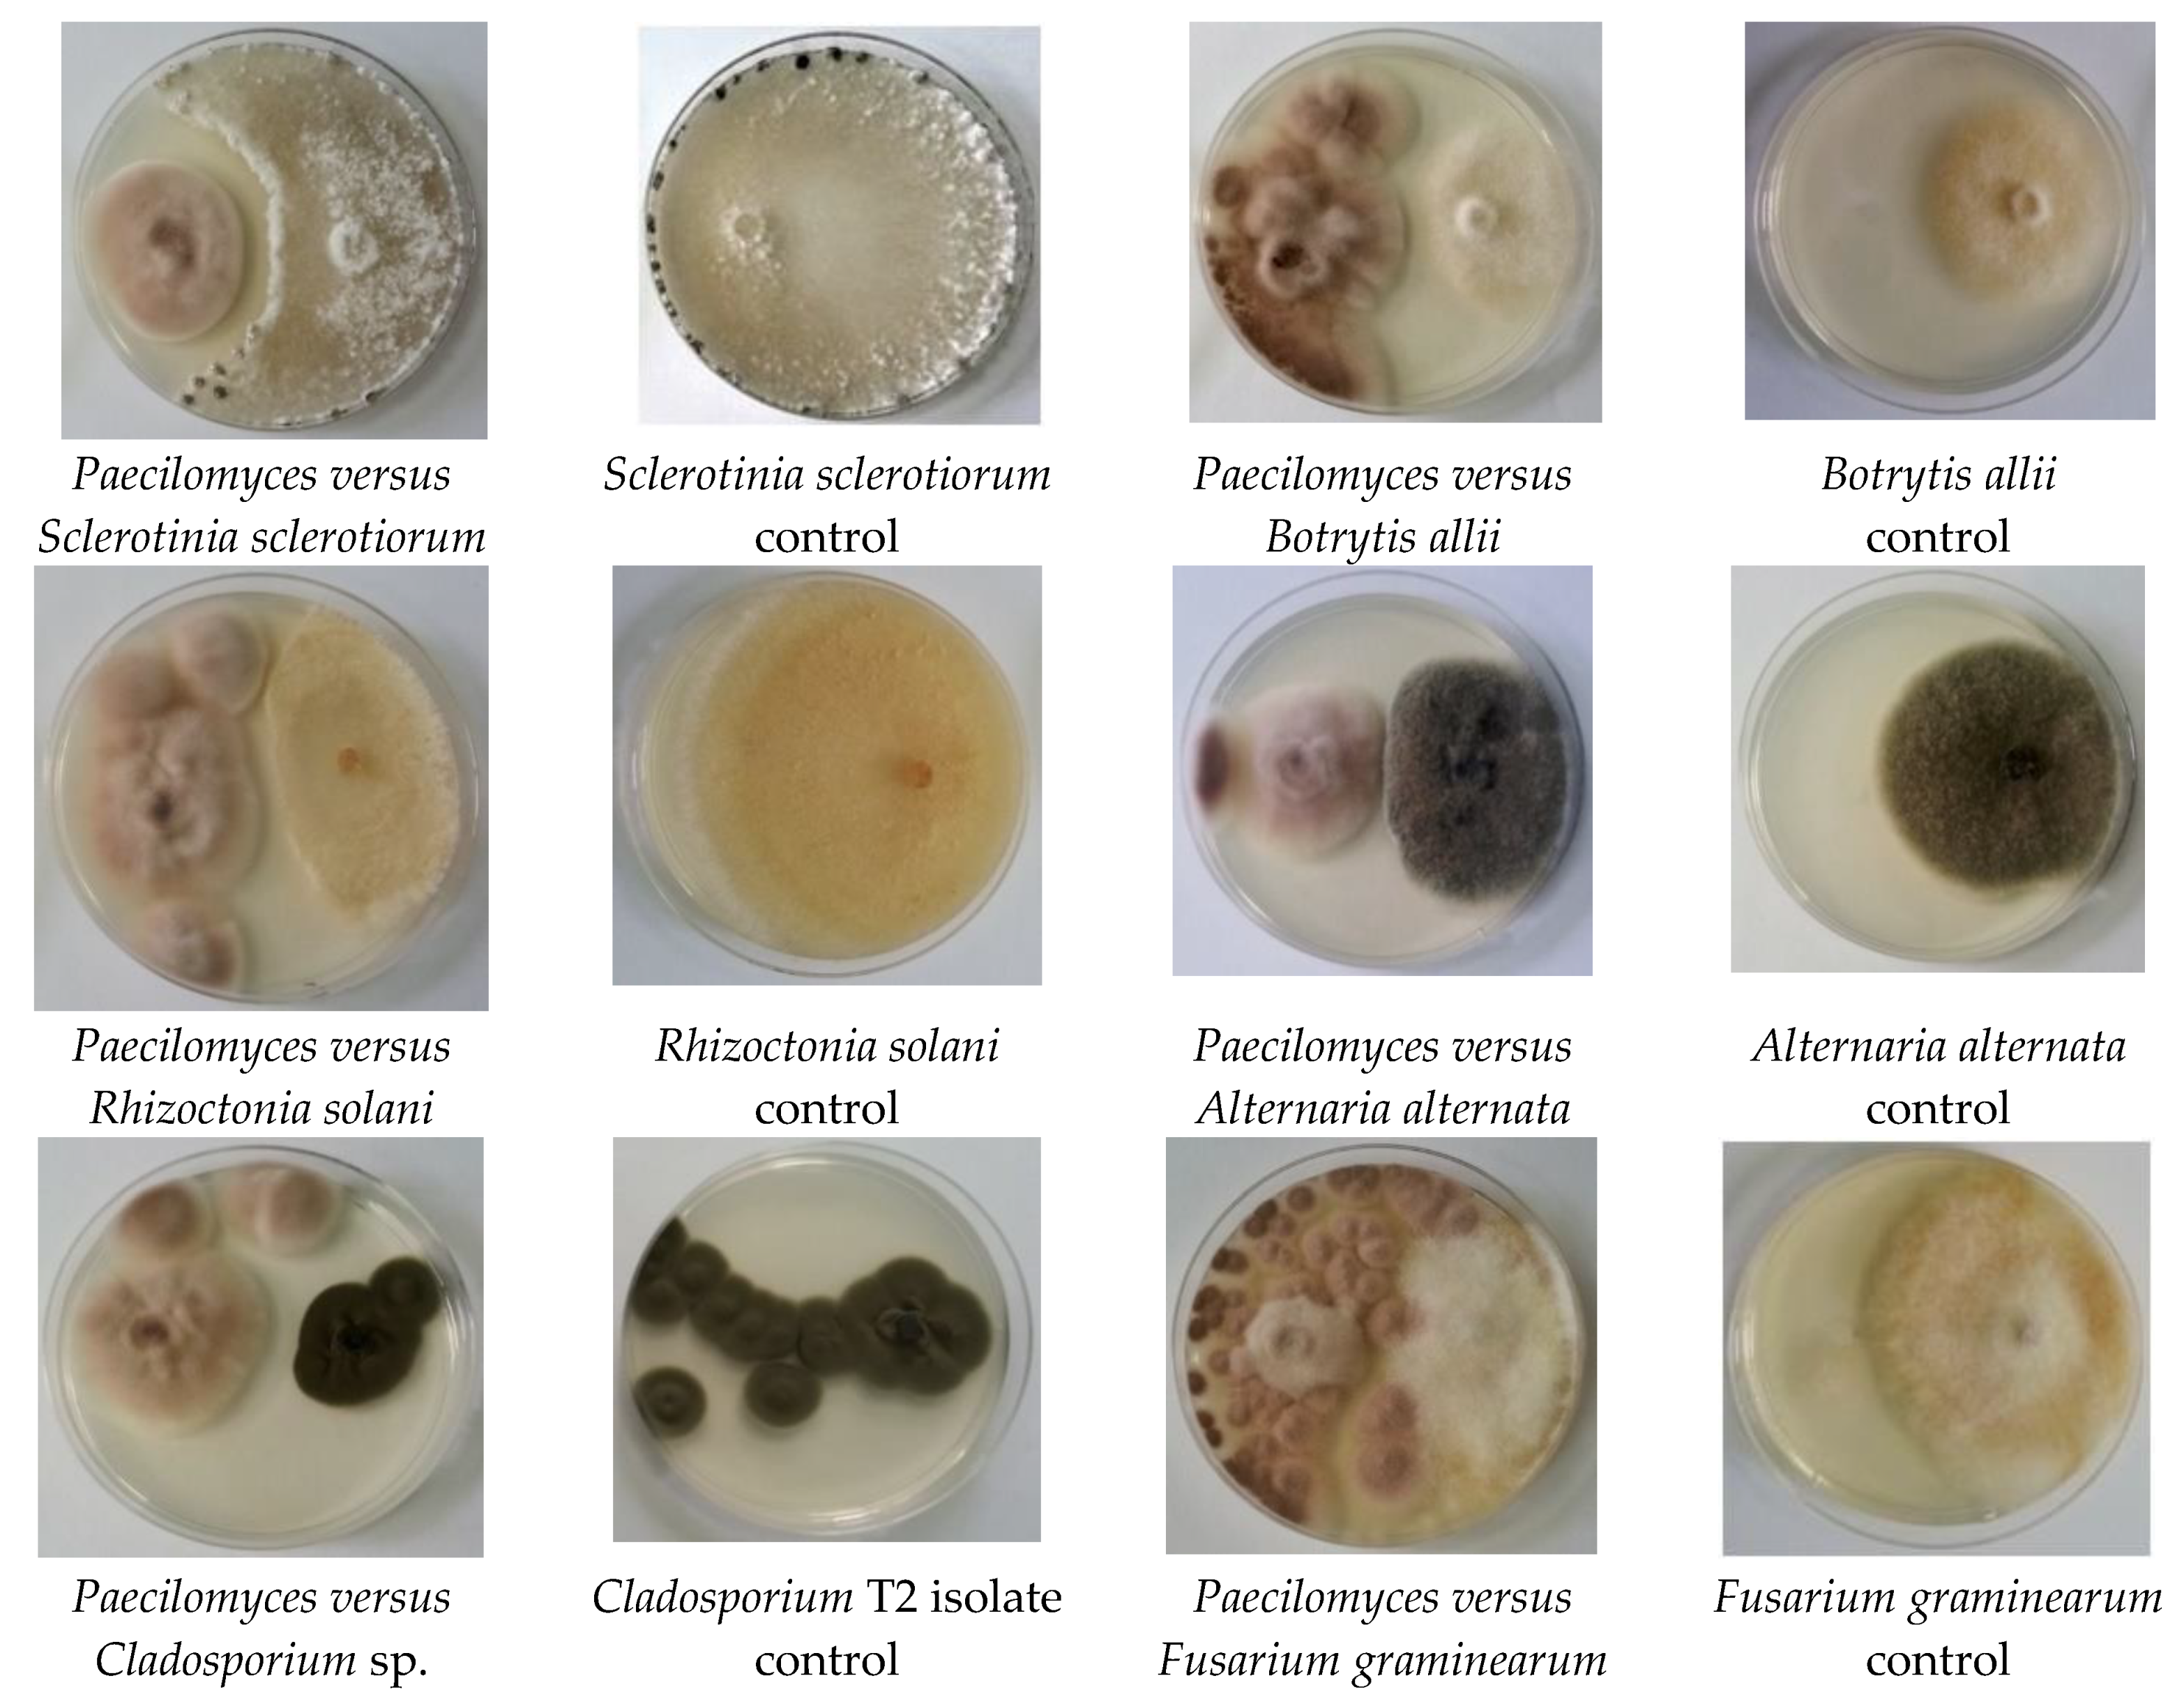
Applsci 12 07572 g002 Applsci 12 07572 g002

Exploring the Potential Applications of Paecilomyceslilacinus 112
Abstract
1. Introduction
2. Materials and Methods
2.1. Microorganisms
2.2. Keratin Substrates (Feathers and Wool)
2.3. Fungal Cultivation for Protein Hydrolyzate (PH) Preparation
2.4. Antagonism versus Plant Pathogenic Fungi
2.5. Enzymatic Activities
2.6. Analysis of Plant Growth-Promoting Characteristics
2.7. Soluble Protein Content of Protein Hydrolyzates
2.8. Scheme Used for Plant Treatments
2.9. Statistical Analysis
3. Results
3.1. Antagonism against Plant Pathogenic Fungi
3.2. Secretion of Hydrolytic Enzymes
3.3. Plant Growth-Promoting Characteristics
3.4. Soluble Protein of Fungal Hydrolyzates
3.5. Effects of PH on Tomato Seedlings
3.6. Statistical Analysis
4. Discussion
5. Conclusions
Author Contributions
Funding
Institutional Review Board Statement
Informed Consent Statement
Data Availability Statement
Acknowledgments
Conflicts of Interest
References
- Yakhin, O.I.; Lubyanov, A.A.; Yakhin, I.A.; Brown, P.H. Biostimulants in Plant Science: A Global Perspective. Front. Plant Sci 2019, 7, 2049. [Google Scholar] [CrossRef]
- Nephali, L.; Piater, L.A.; Dubery, I.A.; Patterson, V.; Huyser, J.; Burgess, K.; Tugizimana, F. Biostimulants for Plant Growth and Mitigation of Abiotic Stresses: A Metabolomics Perspective. Metabolites 2020, 10, 505. [Google Scholar] [CrossRef] [PubMed]
- Du Jardin, P. Plant biostimulants: Definition; concept; main categories and regulation. Sci. Hortic. 2015, 196, 3–14. [Google Scholar] [CrossRef]
- Van Oosten, M.J.; Pepe, O.; De Pascale, S.; Silletti, S.; Maggio, A. The role of biostimulants and bioeffectors as alleviators of abiotic stress in crop plants. Chem. Biol. Technol. Agric. 2017, 4, 5. [Google Scholar] [CrossRef]
- Drobek, M.; Fra, M.; Cybulska, J. Plant Biostimulants: Importance of the Quality and Yield of Horticultural Crops and the Improvement of Plant Tolerance to Abiotic Stress—A Review. Agronomy 2019, 9, 335. [Google Scholar] [CrossRef]
- Reddy, N. Non-food industrial applications of poultry feathers. Waste Manag. 2015, 45, 91–107. [Google Scholar] [CrossRef]
- Tesfaye, T.; Sithole, B.; Ramjugernath, D. Valorisation of chicken feathers: A review on recycling and recovery route—Current status and future prospects. Clean Technol. Environ. Policy 2017, 19, 2363–2378. [Google Scholar] [CrossRef]
- Khumalo, M.; Tesfaye, T.; Sithole, B.; Ramjugernath, D. Possible Beneficiation of Waste Chicken Feathers via Conversion into Biomedical Applications. Int. J. Chem. Sci. 2019, 17, 298. [Google Scholar] [CrossRef]
- Šafari, R.; Zemljič, L.F.; Novak, M.; Dugonik, B.; Bratina, B.; Gubeljak, N.; Bolka, S.; Strnad, S. Preparation and Characterisation of Waste Poultry Feathers Composite Fibreboards. Materials 2020, 13, 4964. [Google Scholar] [CrossRef] [PubMed]
- Marchelli, F.; Rovero, G.; Curti, M.; Arato, E.; Bosio, B.; Moliner, C. An Integrated Approach to Convert Lignocellulosic and Wool Residues into Balanced Fertilisers. Energies 2021, 14, 497. [Google Scholar] [CrossRef]
- Rajabinejad, H.; Bucişcanu, I.I.; Maier, S.S. Current approaches for raw wool waste management and unconventional valorization: A review. Environ. Eng. Manag. J. 2019, 18, 1439–1456. [Google Scholar]
- He, Z.; Sun, R.; Tang, Z.; Bu, T.; Wu, Q.; Li, C.; Chen, H. Biodegradation of Feather Waste Keratin by the Keratin-Degrading Strain Bacillus subtilis 8. J. Microbiol. Biotechnol. 2018, 28, 314–322. [Google Scholar] [CrossRef] [PubMed]
- Joardar, J.C.; Rahman, M.M. Poultry feather waste management and effects on plant growth. Int. J. Recycl. Org. Waste Agric. 2017, 7, 183–188. [Google Scholar] [CrossRef]
- Ghaffar, I.; Imtiaz, A.; Hussain, A.; Arshad Javid, A.; Jabeen, F.; Akmal, M.; Qaz, J.I. Microbial production and industrial applications of keratinases: An overview. Int. Microbiol. 2018, 21, 163–174. [Google Scholar] [CrossRef] [PubMed]
- Mousa, W.K.; Raizada, M.N. The diversity of anti-microbial secondary metabolites produced by fungal endophytes: An interdisciplinary perspective. Front. Microbiol. 2013, 4, 65. [Google Scholar] [CrossRef] [PubMed]
- Fadiji, A.E.; Babalola, O.O. Exploring the potentialities of beneficial endophytes for improved plant growth. Saudi J. Biol. Sci. 2020, 27, 3622–3633. [Google Scholar] [CrossRef]
- Dai, Z.B.; Wang, X.; Hong, G. Secondary Metabolites and Their Bioactivities Produced by Paecilomyces. Molecules 2020, 25, 5077. [Google Scholar] [CrossRef]
- Akpor, O.B.; Odesola, D.E.; Thomas, R.E.; Oluba, O.M. Chicken feather hydrolysate as alternative peptone source for microbial cultivation. F1000Research 2019, 7, 1918. [Google Scholar] [CrossRef]
- Islam, M.A.; Nain, Z.; Alam, M.K.; Banu, N.A.; Islam, M.R. In vitro study of biocontrol potential of rhizospheric Pseudomonas aeruginosa against Fusarium oxysporum f. sp. Cucumerinum. Egypt. J. Biol. Pest Control 2018, 28, 90. [Google Scholar] [CrossRef]
- Sakpetch, P.; Aran, H.; Kuwahara, Y.; Komeda, H.; Asano, Y. Isolation of indigenous antagonistic microorganism to inhibit Rigidoporus microporus and other plant pathogens and analysis of the bioactive compounds. Biol. Control 2018, 124, 53–60. [Google Scholar] [CrossRef]
- Yoon, J.H.; Park, J.E.; Dong, Y.S.; Hong, S.B.; Ko, S.J.; Kim, S.H. Comparison of dyes for easy detection of extracellular cellulases in fungi. Mycobiology 2007, 35, 21–24. [Google Scholar] [CrossRef][Green Version]
- Lateefa, A.; Adelerea, I.A.; Gueguim-Kana, B.E.B. Bacillus safensis LAU 13: A new source of keratinase and its multi-functional biocatalytic applications. Biotechnol. Biotechnol. Equip. 2015, 29, 5463. [Google Scholar] [CrossRef]
- Anitha, S.; Padma, D.S.N.; Sunith, K.K. Isolation and identification of zinc solubilizing fungal isolates from agricultural fields. Indian J. Agric. Sci. 2015, 85, 1638–1642. [Google Scholar]
- Kaur, G.; Reddy, M.S. Role of Phosphate-Solubilizing Fungi in Sustainable Agriculture. In Developments in Fungal Biology and Applied Mycology; Satyanarayana, T., Deshmukh, S., Johri, B., Eds.; Springer: Singapore, 2017; pp. 391–412. [Google Scholar] [CrossRef]
- Carvajal, L.; Orduz, S.; Bissett, J. Growth stimulation in bean (Phaseolus vulgaris L.) by Trichoderma. Biol. Control. 2009, 51, 409–416. [Google Scholar] [CrossRef]
- Lowry, O.H.; Rosebrough, N.J.; Farr, A.; Randall, R.J. Protein measurement with the folin phenol reagent. J. Biol. Chem. 1951, 193, 256–275. [Google Scholar] [CrossRef]
- Li, X.Q.; Xu, K.; Liu, X.M.; Zhang, P. Systematic Review on Secondary Metabolites of Paecilomyces Species: Chemical Diversity and Biological Activity. Planta Med. 2020, 86, 805–821. [Google Scholar] [CrossRef]
- Suárez-Estrella, F.; Arcos-Nievas, M.A.; López, M.J.; Vargas-García, M.C.; Moreno, J. Biological control of plant pathogens by microorganisms isolated from agro-industrial composts. Biol. Control 2013, 67, 509–515. [Google Scholar] [CrossRef]
- Nesha, R.; Siddiqui, Z.A. Effects of Paecilomyces lilacinus and Aspergillus niger alone and in combination on the growth, chlorophyll contents and soft rot disease complex of carrot. Sci. Hortic. 2017, 218, 258–264. [Google Scholar] [CrossRef]
- Varma, P.K.; Gandhi, S.K.; Surender, S. Biological control of Alternaria solani, the causal agent of early blight of tomato. J. Biol. Control 2008, 22, 67–72. [Google Scholar]
- Sivakumar, T.; Eswaran, A.; Balabaskar, P. Bioefficacy of antagonists against for the management of Fusarium oxysporum f. sp. lycopersici and Meloidogyne incognita disease complex of tomato under field condition. Plant Arch. 2008, 8, 373–377. [Google Scholar]
- Yang, F.; Abdelnabby, H.; Xiao, Y. A mutant of the nematophagous fungus Paecilomyces lilacinus (Thom) is a novel biocontrol agent for Sclerotinia sclerotiorum. Microb. Pathog. 2015, 89, 169–176. [Google Scholar] [CrossRef]
- Al-Hazmi, A.S.; Dawabah, A.A.M.; Al-Nadhari, S.N.; Al-Yahya, F.A. Comparative efficacy of different approaches to managing Meloidogyne incognita on green bean. Saudi J. Bio. Sci. 2017, 24, 149–154. [Google Scholar] [CrossRef][Green Version]
- Dahlin, P.; Eder, R.; Consoli, E.; Krauss, J.; Kiewnick, S. Integrated control of Meloidogyne incognita in tomatoes using fluopyram and Purpureocillium lilacinum strain 251. Crop Prot. 2019, 124, 104874. [Google Scholar] [CrossRef]
- Moreno-Gavíra, A.; Huertas, V.; Diánez, F.; Sánchez-Montesinos, B.; Santos, M. Paecilomyces and Its Importance in the Biological Control of Agricultural Pests and Diseases. Plants 2020, 9, 1746. [Google Scholar] [CrossRef]
- Moreno-Gavíra, A.; Diánez, F.; Sánchez-Montesinos, B.; Santos, M. Biocontrol Effects of Paecilomyces variotii against Fungal Plant Diseases. J. Fungi 2021, 7, 415. [Google Scholar] [CrossRef] [PubMed]
- Lu, C.; Liu, H.; Jiang, D.; Wang, L.; Jiang, Y.; Tang, S.; Hou, X.; Han, X.; Chu, Z.; Ding, X. Paecilomyces variotii extracts (ZNC) enhance plant immunity and promote plant growth. Plant Soil 2019, 441, 383–397. [Google Scholar] [CrossRef]
- Rauwane, M.E.; Ogugua, U.V.; Kalu, C.M.; Ledwaba, L.K.; Woldesemayat, A.A.; Ntushelo, K. Pathogenicity and Virulence Factors of Fusarium graminearum Including Factors Discovered Using Next Generation Sequencing Technologies and Proteomics. Microorganisms 2020, 8, 305. [Google Scholar] [CrossRef] [PubMed]
- Hussein, M.; Hassan, M.; Abo-Elyousr, K.A.M. Biological control of Botrytis allii by Trichoderma viride on onion (Allium cepa). World Appl. Sci. J. 2014, 32, 522–526. [Google Scholar] [CrossRef]
- Erlacher, A.; Cardinale, M.; Grosch, R.; Grube, M.; Berg, G. The impact of the pathogen Rhizoctonia solani and its beneficial counterpart Bacillus amyloliquefaciens on the indigenous lettuce microbiome. Front. Microbiol. 2014, 5, 175. [Google Scholar] [CrossRef] [PubMed]
- Swett, C.L.; Hamby, K.A.; Hellman, E.M.; Carignan, C.; Bourret, T.B.; Koivunen, E.E. Characterizing members of the Cladosporium cladosporioides species complex as fruit rot pathogens of red raspberries in the mid-Atlantic and co-occurrence with Drosophila suzukii (spotted wing drosophila). Phytoparasitica 2019, 47, 415–428. [Google Scholar] [CrossRef]
- Meena, M.; Gupta, S.K.; Swapnil, P.; Zehra, A.; Dubey, M.K.; Upadhyay, R.S. Alternaria Toxins: Potential Virulence Factors and Genes Related to Pathogenesis. Front. Microbiol. 2017, 8, 1451. [Google Scholar] [CrossRef] [PubMed]
- Rivas, S.; Thomas, C.M. Molecular Interactions Between Tomato and the Leaf Mold Pathogen Cladosporium fulvum. Ann. Rev. Phytopathol. 2005, 43, 395–436. [Google Scholar] [CrossRef] [PubMed]
- Demirci, E.; Dane, E.; Eken, C. In vitro antagonistic activity of fungi isolated from sclerotia on potato tubers against Rhizoctonia solan. Turk. J. Biol. 2011, 35, 457–462. [Google Scholar] [CrossRef]
- Abegaz, B.M.; Kinfe, H.H. Secondary metabolites, their structural diversity, bioactivity, and ecological functions: An overview. Phys. Sci. Rev. 2019, 4, 20180100. [Google Scholar] [CrossRef]
- Shuikan, A.M.; Hozzein, W.N.; Alzharani, M.M.; Sandouka, M.N.; Al Yousef, S.A.; Alharbi, S.A.; Damra, E. Enhancement and Identification of Microbial Secondary Metabolites. In Extremophilic Microbes and Metabolites—Diversity, Bioprospecting and Biotechnological Applications; Afef, N., Ameur, C., Haïtham, S., Hadda, I.O., Eds.; IntechOpen: London, UK, 2020. [Google Scholar] [CrossRef]
- Saha, M.; Sarkar, S.; Sarkar, B.; Sharma, B.K.; Bhattacharjee, S.; Tribedi, P. Microbial siderophores and their potential applications: A review. Environ. Sci. Pollut. Res. 2016, 23, 3984–3999. [Google Scholar] [CrossRef]
- Holinsworth, B.; Martin, J.D. Siderophore production by marine derived fungi. BioMetals 2009, 22, 625–632. [Google Scholar] [CrossRef]
- Renshaw, J.C.; Robson, G.D.; Trinci, A.P.; Wiebe, M.G.; Livens, F.R.; Collison, D.; Taylor, R.J. Fungal siderophores: Structures, functions and applications. Mycol. Res. 2002, 106, 1123–1142. [Google Scholar] [CrossRef]
- Billah, M.; Khan, M.; Bano, A.; Ul Hassan, T.; Asia Munir, A.; Gurmani, A.R. Phosphorus and phosphate solubilizing bacteria: Keys for sustainable agriculture. Geomicrobiol. J. 2019, 36, 904–916. [Google Scholar] [CrossRef]
- Mitra, D.; Snđelković, S.; Panneerselvam, P.; Senapati, A.; Vasić, T.; Ganeshamurthy, A.N.; Chauhan, M.; Uniyal, N.; Mahakur, B.; Radha, T.K. Phosphate-Solubilizing Microbes and Biocontrol Agent for Plant Nutrition and Protection: Current Perspective. Commun. Soil Sci. Plant. Anal. 2020, 51, 645–657. [Google Scholar] [CrossRef]
- Ahuja, A.; D’Souza, F.D. Bioprocess for Solubilization of Rock Phosphate on Starch Based Medium by Paecilomyces marquandii Immobilized on Polyurethane Foam. Appl. Biochem. Biotechnol. 2009, 152, 1. [Google Scholar] [CrossRef] [PubMed]
- Kushwaha, P.; Kashyap, P.L.; Pandiyan, K.; Bhardwaj, A.K. Zinc-Solubilizing Microbes for Sustainable Crop Production: Current Understanding, Opportunities, and Challenges. In Phytobiomes. Current Insights and Future Vistas; Solanki, M., Kashyap, P., Kumari, B., Eds.; Springer: Singapore, 2020; pp. 281–298. [Google Scholar] [CrossRef]
- Bhatt, K.; Maheshwari, D.K. Zinc solubilizing bacteria (Bacillus megaterium) with multifarious plant growth promoting activities alleviates growth in Capsicum annuum L. 3 Biotech 2020, 36, 10. [Google Scholar] [CrossRef] [PubMed]
- Farouk, H.M.; Attia, E.Z.; El-Katatny, M.H. Hydrolytic enzyme production of endophytic fungi isolated from soybean (Glycine max). J. Mod. Res. 2020, 2, 1–7. [Google Scholar] [CrossRef]
- Lopez-Llorca, L.V.; Carbonell, T.; Gomez-Vidal, S. Degradation of insect cuticle by Paecilomyces farinosus proteases. Mycol. Prog. 2002, 1, 249–256. [Google Scholar] [CrossRef]
- Cavello, I.A.; Crespo, J.M.; García, S.S.; Zapiola, J.M.; Luna, M.F.; Cavalitto, S.F. Plant growth promotion activity of keratinolytic fungi growing on a recalcitrant waste known as Hair Waste. Biotechnol. Res. Intern. 2015, 6, 1–10. [Google Scholar] [CrossRef] [PubMed]
- Mishra, P.; Mishra, J.; Dwivedi, S.K.; Arora, N.K. Chapter 10. Microbial Enzymes in Biocontrol of Phytopathogens. In Microbial Enzymes: Roles and Applications in Industries Microorganisms for Sustainability 11; Arora, N.K., Mishra, J., Mishra, V., Eds.; Springer Nature Singapore Pte Ltd.: Berlin/Heidelberg, Germany, 2020; pp. 259–285. [Google Scholar] [CrossRef]
- Roblet, D.; Delabona, P.S.; Mergel, C.M.; Rojas, J.D.; Costa, P.S.; Pimente, I.C.; Vicente, V.A.; Pradella, J.G.; Padilla, G. The capability of endophytic fungi for production of hemicellulases and related enzymes. BMC Biotechnol. 2013, 13, 94. [Google Scholar] [CrossRef]
- Correa, R.C.G.; Rhoden, S.A.; Mota, T.R.; Azevedo, J.L.; Pamphile, J.A.; Souza, C.G.M.; Polizeli, M.L.T.M.; Bracht, A.; Peralta, R.M. Endophytic fungi: Expanding the arsenal of industrial enzyme producers. J. Ind. Microbiol. Biotechnol. 2014, 41, 1467–1478. [Google Scholar] [CrossRef]
- Vesela, M.; Friederich, J. Amino Acid and Soluble Protein Cocktail from Waste Keratin Hydrolysed by a Fungal Keratinase of Paecilomyces marquandii. Biotechnol. Bioprocess. Eng. 2009, 14, 84–90. [Google Scholar] [CrossRef]
- Wang, Q.; Peng, C.; Shi, L.; Liu, Z.; Zhou, D.; Meng, H.; Zhao, H.; Li, F.; Zhang, M. A Technical System for the Large-Scale Application of Metabolites from Paecilomyces variotii SJ1 in Agriculture. Front. Bioeng. Biotechnol. 2021, 9, 671879. [Google Scholar] [CrossRef] [PubMed]
- Baron, N.C.; de Souza Pollo, A.; Rigobelo, E.C. Purpureocillium lilacinum and Metarhizium marquandii as plant growth-promoting fungi. PeerJ 2020, 8, e9005. [Google Scholar] [CrossRef] [PubMed]
- Chen, Q.; Li, Z.; Qu, Z.; Zhou, H.; Qi, Y.; Liu, Z.; Zhang, M. Maize yield and root morphological characteristics affected by controlled-release diammonium phosphate and Paecilomyces variotii extracts. Field Crops Res. 2020, 255, 107862. [Google Scholar] [CrossRef]

| Antagonistic Fungal Isolate | Pathogenic Fungi | Diameter of Pathogen Colony in Presence of Antagonist (cm) * | Diameter of Pathogen Colony (Control) (cm) * | Inhibition of Tested Pathogens (%) |
|---|---|---|---|---|
| Paecilomyces lilacinus 112 | Rhizoctonia solani | 3.8 ± 0.1 | 8.0 ± 0.1 | 52.5 ± 2.1 |
| Sclerotinia sclerotiorum. | 4.2 ± 0.1 | 8.5 ± 0.1 | 50.2 ± 1.7 | |
| Fusarium graminearum | 3.0 ± 0.1 | 5.8 ± 0.1 | 47.1 ± 1.9 | |
| Botrytis allii | 3.6 ± 0.1 | 5.1 ± 0.2 | 29.4 ± 1.9 | |
| Cladosporium T2 | 2.7 ± 0.1 | 8.1 ± 0.1 | 66.3 ± 1.3 | |
| Alternaria alternata | 4.0 ± 0.1 | 5.9 ± 0.1 | 32.2 ± 1.7 |
| Protein Hydrolyzate | Soluble Protein (mg/mL) |
|---|---|
| Paecilomyces lilacinus 112 cultivated on feather medium | 0.230 |
| Paecilomyces lilacinus 112 cultivated on wool medium | 0.110 |
| Paecilomyces lilacinus 112 cultivated on medium without keratin (control) | 0.002 |
| Plant Treatments | Growth Parameters of Plants | ||||
|---|---|---|---|---|---|
| Biomass * (g) | Plant Height * (cm) | Plant Diameter * (mm) | Number of Branches/Plants * | Number of Leaves/Plants * | |
| Treatment with PH obtained from Paecilomyces lilacinus cultured on feather medium | 1.8 ± 0.2 | 26.6 ± 0.4 | 2.9 ± 0.3 | 7.0 ± 0.3 | 34.3 ± 0.3 |
| Treatment with PH obtained from Paecilomyces lilacinus cultured on wool medium | 1.6 ± 0.3 | 27.8 ± 0.4 | 2.8 ± 0.2 | 6.0 ± 0.3 | 29.3 ± 0.4 |
| Treatment with water | 0.5 ± 0.3 | 8.1 ± 0.3 | 2.2 ± 0.2 | 4.6 ± 0.2 | 24.0 ± 0.3 |
Publisher’s Note: MDPI stays neutral with regard to jurisdictional claims in published maps and institutional affiliations. |
© 2022 by the authors. Licensee MDPI, Basel, Switzerland. This article is an open access article distributed under the terms and conditions of the Creative Commons Attribution (CC BY) license (https://creativecommons.org/licenses/by/4.0/).
Share and Cite
Constantin, M.; Raut, I.; Gurban, A.-M.; Doni, M.; Radu, N.; Alexandrescu, E.; Jecu, L. Exploring the Potential Applications of Paecilomyceslilacinus 112. Appl. Sci. 2022, 12, 7572. https://doi.org/10.3390/app12157572
Constantin M, Raut I, Gurban A-M, Doni M, Radu N, Alexandrescu E, Jecu L. Exploring the Potential Applications of Paecilomyceslilacinus 112. Applied Sciences. 2022; 12(15):7572. https://doi.org/10.3390/app12157572
Chicago/Turabian StyleConstantin, Mariana, Iuliana Raut, Ana-Maria Gurban, Mihaela Doni, Nicoleta Radu, Elvira Alexandrescu, and Luiza Jecu. 2022. "Exploring the Potential Applications of Paecilomyceslilacinus 112" Applied Sciences 12, no. 15: 7572. https://doi.org/10.3390/app12157572
APA StyleConstantin, M., Raut, I., Gurban, A.-M., Doni, M., Radu, N., Alexandrescu, E., & Jecu, L. (2022). Exploring the Potential Applications of Paecilomyceslilacinus 112. Applied Sciences, 12(15), 7572. https://doi.org/10.3390/app12157572

